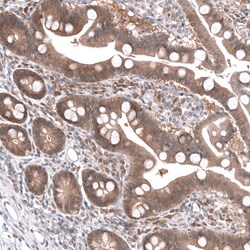
Invitrogen SAPK4 Polyclonal Antibody 100 &mu;L; Unconjugated:Antibodies,

missing translation for 'onlineSavingsMsg'
Learn More
Learn More
Invitrogen™ SAPK4 Polyclonal Antibody


Rabbit Polyclonal Antibody
Brand: Invitrogen™ PA552465
This item is not returnable.
View return policy
Description
Immunogen sequence: KTLFKGKDYL DQLTQILKVT GVPGTEFVQK LNDKAAKSYI QSLPQTPRKD FTQLFPRASP QAADLLEKML ELDVDKRLTA AQALTHPFFE PFRDPEEETE AQQPFDDSLE HEKLTVDEWK QHIYKEIVNF SPIARKDS Highest antigen sequence identity to the following orthologs: Mouse - 93%, Rat - 92%.
MAPK13 (p38 delta) is a serine/threonine kinase that transduces a variety of extracellular signals, including cytokine and environmental stress responses. MAPK13 also regulates the differentiation of keratinocytes. This kinase is activated by various environmental stresses and proinflammatory cytokines. The activation requires its phosphorylation by MAP kinase kinases, or its autophosphorylation triggered by the interaction of MAP3K7IP1/TAB1 protein with this kinase. The substrates of this kinase include transcription regulator ATF2, MEF2C, and MAX, cell cycle regulator CDC25B, and tumor suppressor p53, which suggest the roles of this kinase in stress related transcription and cell cycle regulation, as well as in genotoxic stress response. Four alternatively spliced transcript variants of SAPK4 encoding distinct isoforms have been reported.
Specifications
| SAPK4 | |
| Polyclonal | |
| Unconjugated | |
| MAPK13 | |
| im:7136778; MAP kinase 13; MAP kinase p38 delta; MAPK 13; Mapk13; MAPK-13; mitogen activated protein kinase 13; mitogen-activated protein kinase 13; Mitogen-activated protein kinase p38 delta; p38 delta MAP kinase; p38delta; PRKM13; SAPK/Erk/kinase 4; SAPK4; Serk4; Stress-activated protein kinase 4 | |
| Rabbit | |
| Antigen affinity chromatography | |
| RUO | |
| 5603 | |
| Store at 4°C short term. For long term storage, store at -20°C, avoiding freeze/thaw cycles. | |
| Liquid |
| Immunohistochemistry (Paraffin), Western Blot | |
| 0.2 mg/mL | |
| PBS with 40% glycerol and 0.02% sodium azide; pH 7.2 | |
| O15264 | |
| MAPK13 | |
| Recombinant protein corresponding to Human p38 MAPK delta. Recombinant protein control fragment (Product #RP-89798). | |
| 100 μL | |
| Primary | |
| Human | |
| Antibody | |
| IgG |
Product Content Correction
Your input is important to us. Please complete this form to provide feedback related to the content on this product.
Product Title
Spot an opportunity for improvement?Share a Content Correction